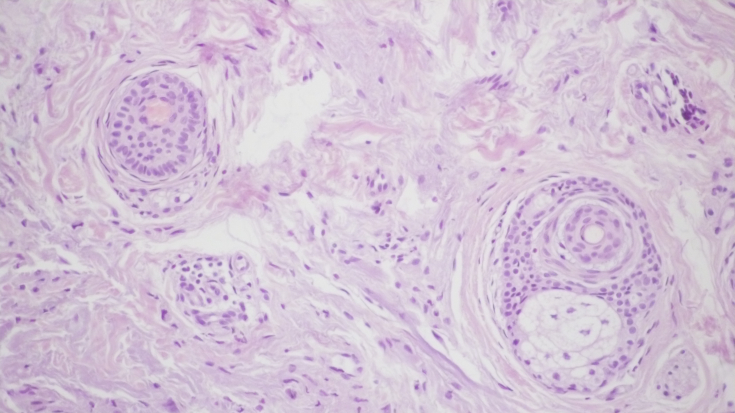

Будучи природним зовнішнім бар'єром, шкіра виконує щомиті ряд узгоджених дій, спрямованих на захист організму від стресів, підтримку гомеостазу і постійне оновлення дермо-епідермальних клітин. Основними ознаками вікових змін шкіри є уповільнення загоєння рани, збільшення випадків злоякісного переродження, підвищена ламкість її структур. Профілактика і вирішення питань anti-age терапії засновані на глибокому розумінні основних процесів відхилень і дисфункцій в ключових компонентах шкіри. Довгий час зовнішні і внутрішні пошкодження розглядалися як вирішальні в процесі старіння і тільки недавно були відкриті молекулярні механізми, які відіграють вирішальну роль в роботі і зовнішніх проявах змін шкіри, що з'являються з віком.
Велика частка вікових змін регулюється накопиченням пошкоджених молекул і органел, кількість яких регулюється процесами аутофагії. Геномна нестабільність, чутливість до поживних речовин, підтримка синтезу і розпаду внутрішньоклітинного білка активізують аутофагію, роблячи її незамінним процесом в підтримці гомеостазу шкіри і відновленні хімічних процесів, характерних для молодої тканини.
Активація процесу аутофагії: клінічні дослідження
Автор
Анастасія Свиридова - медичний директор Adassa Medical Clinic (Дніпро), дерматолог, косметолог, сертифікований тренер Sinclair Pharma, сертифікований тренер міжнародного класу EMET Medicine, член МАЕКМ (Міжнародна асоціація естетичної косметології та мезотерапії)

Аутофагія - природний процес внутрішньоклітинного перетравлення пошкодженого цитоплазматичного матеріалу всередині лізосом або вакуолей.
Існує три основних механізми, за допомогою яких відбуваються процеси самоперетравлення. При мікроавтофагії лізосомами перетворюються пошкоджені ділянки клітинних мембран і дефектні органели. Макроаутофагія заснована на перетравленні мітохондрій і рибосом шляхом поглинання вузла цитопазми аутофагосоми з подальшим злиттям її з лізосомою і лізисом вмісту. При шаперонової аутофагії, яка характерна тільки для ссавців, пошкоджені і частково денатуровані білки цілеспрямовано направляються в лізосоми, де руйнуються відповідними ферментами. Процеси аутофагії стимулюються стресом, таким як фізичні навантаження і голодування, і частково залежать від генетичних особливостей активності генів, які стимулюють або пригнічують всі основні етапи самоочищення. Також виділення внутрішніх генів, що регулюють аутофагію, залежить від циркадних ритмів і віку.
У великій кількості клінічних досліджень доведено два основних моменти впливу аутофагії на старіння:
- аутофагія значно знижує швидкість старіння клітин
- активність процесів аутофагії знижується з віком
Більшість зарубіжних статей довели вплив аутофагії на стовбурові клітини. Ті клітини-попередники, які перебувають у стані спокою, потребують процесів самоочищення, щоб підтримувати внутрішньоклітинний гомеостаз і здатність постачати нові високодиференційовані клітини. Саме цей процес може бути пов'язаний з нормальною регенерацією, а значить, і оновленням шкіри. Порушення процесів аутофагії надійно призводить до накопичення пошкоджених, іноді токсичних компонентів і енергетичної кризи клітини.
Єдиним препаратом, що здатен активізувати та підтримати всі стадії процесу аутофагії, відновити працездатність клітин шкіри, підсилити місцевий імунітет та протизапальний ефект, забезпечити клітини достатньою кількістю енергії – є COREBANIC™ (Корбанік). Це інноваційна ін'єкційна косметична технологія від лабораторії ABG LAB (США), завдяки якій можна отримати гарантований видимий ефект ревіталізації та покращення стану шкіри вже на 4 день після ін‘єктування, а також підсилити ефект від усіх естетичних процедур.
На базі приватного косметологічного центру Adassa Medical Clinic було проведено постмаркетингове обмежене клінічне випробування ефективності та безпеки лікування вікових змін шкіри в складних косметичних процедурах за допомогою ін'єкційного препарату Corebanic . У дослідженні взяли участь 4 пацієнтки з різними типами вікових змін. Всі вони отримали індивідуальні схеми омолодження шкіри шиї і підщелепної зони.
Критерії включення пацієнтів в дослідження:
- Наявність вікових змін шкіри, тобто показань до терапії
- Бажання пацієнтів брати участь у дослідженні, підтверджене підписанням протоколу добровільної інформованої згоди
Критерії виключення пацієнтів з дослідження
- Соматичні захворювання в стадії декомпенсації
- Гострі інфекційні захворювання на момент проведення процедур
- Непереносимість компонентів препарату
- Намір отримати будь-які інші косметичні маніпуляції під час курсу
Пацієнт 1, 69 років, дрібноморщений тип старіння, зміни зв'язкового апарату, втрата тургору і еластичності шкіри, низька реакція на стимулюючі косметичні процедури
Отримала монотерапію Коребаніком по 2 мл в кількості 3 процедур з різницею в 14 днів. Ін'єкції проводилися в глибокі шари дерми до появи горбка на відстані 1 см Результати процедури включали фотодокументацію, суб'єктивну оцінку пацієнта і об'єктивну оцінку дослідженням перфораторної біопсії місця дерми до і після введення відповідного препарату. Результати дослідження були проведені через 14 днів після останнього прийому.
Суб'єктивна оцінка пацієнта за п'ятибальною шкалою задоволеності пацієнта, де 1 не повністю задоволений і 5 повністю задоволений, склала 5.

Інструментальною діагностикою дослідження слугувало патогісхімічне дослідження та порівняння біоптатів шкіри, що була взята шляхом панч – биопсії в підщелепній області.
При контрольній гістологічній підготовці ділянки шкіри перед проведенням лікувальних заходів відзначалася вогнищева значно виражена запальна інфільтрація в дермі у вигляді вогнищевих скупчень лімфоцитів і гістіоцитів. (мал. 1а, b). Проліферація дрібних судин капілярного і синусоїдного типу супроводжувалася периваскулярною лімфоїдно-клітинною інфільтрацією (мал. 1c). Навколо окремих волосяних фолікулів і сальних залоз запальна інфільтрація стимулювала проліферацію фібробластів і розвиток склеротичних процесів. (мал. 1d).


Мал. 1. Морфологічна картина шкіри перед лікувальними заходами: вогнищева запальна інфільтрація дерми, х200; запальна інфільтрація навколо волосяних фолікулів, ознаки фіброзу, х200; проліферація дрібних судин капілярного типу з периваскулярної лімфоїдно-клітинною інфільтрацією, х200; сальні залози з вогнищевою запальною інфільтрацією в прилягаючій дермі, х200.
У шкірі пацієнта після монотерапії пептидним препаратом спостерігалося значне зниження запальної інфільтрації (мал. 2а, b). Спостерігалася незначна, переважно периваскулярна лімфоїдна інфільтрація клітин, рідше з'являлися окремі комплекси запальних елементів, розташовані біля придатків шкіри.


Мал. 2. Морфологічна картина шкіри після введення пептидного препарату: запальна інфільтрація дерми виражена набагато менше, х200; в дермі дрібні капіляри зі слабкою периваскулярною лімфоїдно-клітинною інфільтрацією, х200.
Пацієнт 2, 60 років. Втомлений морфотип старіння, стан після ендоскопічного SMAS-ліфтингу в 2008 році. Зміна системи мікроциркуляції, тургору шкіри, виражені прояви окисного стресу в шкірі.
Схеми терапевтичного впливу включили триразове проведення апаратних процедур мікрогольчатого радіохвильового ліфтингу на апараті Infini 1,2, Lutronic с частотою 1 раз на 28-32 днів та триразове введення препарату Corebanic через 13-16 днів у якості первинної процедури та після кожного апаратного впливу в техніці внутрішньошкірних папул.
Результати дослідження були проведені через 14 днів після останнього введення шляхом суб'єктивної оцінки, фотодокументації та інструментальної діагностики.
– патогістохімічне дослідження та порівняння біоптатів шкіри, взятих панч
– біопсії в підщелепної області перед процедурами, на шкірі після триразового лікування її виключно радіохвильовими технологіями на тій частині шкіри, де застосовувалися радіохвильові технології в поєднанні з досліджуваним препаратом.
Суб'єктивна оцінка пацієнта за п'ятибальною шкалою задоволеності пацієнта, де 1 не повністю задоволений і 5 повністю задоволений, склала 5
На фото до і після позитивні зміни набагато помітніше, ніж у випадку з монотерапією.

За даними інструментального дослідження, в комбінованій схемі апаратно-ін'єкційного ефекту зникла лімфоїдно-клітинна інфільтрація дерми, що свідчить про чітку синергію обраних методик в схемі комплексного anti-age рішення для вікової шкіри.

Мал. 3. Морфологічна картина шкіри перед проведенням лікувальних заходів: виражена вогнищева запальна інфільтрація дерми, х200; запальна інфільтрація навколо волосяних фолікулів, ознаки фіброзу, х200; проліферація дрібних судин капілярного типу з периваскулярної лімфоїдно-клітинною інфільтрацією, х200;
Мал.4. Ізольований радіохвильовий вплив на шкіру. Збереження запальних елементів на фоні зниження лімфоїдно-клітинної інфільтрації дерми при вогнищевій проліферації фібробластів, х200.

Мал.5. Комбіноване введення пептидного препарату і радіохвильового впливу на шкіру. Відсутність лімфоїдно-клітинної інфільтрації дерми з вогнищевою проліферацією фібробластів, х200.
Пациент 3, 59 лет, вікові зміни деформаційно-набрякового типу, виражений набряковий синдром, метаболічний синдром
Застосовувалась естетична корекція шиї і підщелепної області комплексним методом, який полягав у використанні вуглекислотного лазера з довжиною хвилі 10600 нм частотою 1 раз в 28-32 дня та триразове введення препарату Corebanic через 13-16 днів після кожного апаратного впливу в техніці внутрішньошкірних папул. Результат дослідження оцінювався суб'єктивним методом і фотодокументацією.
Згідно відгуками пацієнтки, шкіра після комбінованої методики використання вуглекислотного лазера і препарату Corebanic мала більш підтягнутий вигляд, пацієнт відчуває виражений тонус, зволоження, ліфтинг м'яких тканин і рівний колір епідермісу.
Суб'єктивна оцінка пацієнта за п'ятибальною шкалою задоволеності пацієнта, де 1 задоволений не повністю і 5 повністю задоволений, склала максимум 5 балів.
Оцінюючи результати корекції по фото, можна чітко побачити поліпшення якості шкіри, зменшення глибини заломів і поперечних зморшок.

Пацієнт 4, 72 роки, змішаний тип старіння, виражені інволюційні зміни шкіри, зв'язковий апарат, кістки і м'язи, низька реакція на стимулюючі апаратні процедури.
Терапевтичні схеми включали триразове лікування ербієвим лазером з довжиною хвилі 2940 нм в неабляційному режимі частотою 1 раз в 28-32 дня и триразове введення препарату Corebanic через 13-16 днів після кожного апаратного впливу в техніці внутрішньошкірних папул.
Паралельно з лікуванням пацієнтка приймала рідкі форми колагену і контролювала великий відсоток білка в раціоні.
Результат дослідження оцінювався суб'єктивним методом і фотодокументацією через 30 днів після закінчення програми.
Згідно відгуками пацієнтки, видимі зміни вона отримала після подвійного впливу пептидного препарату Corebanic і одноразової апаратної розминки. Максимальний ефект, який полягав у підвищенні тонусу шкіри, її зоровому ущільнення, був отриманий через три тижні після закінчення курсу процедур. Цей ефект помітно відрізнявся за ступенем тяжкості від раніше виділених апаратних процедур, що розігрівають середні шари дерми.
Судячи з фото оброблених ділянок, добре видно позитивні зміни шкіри, незважаючи на розвинені інволюційні процеси, відповідні віку пацієнта.

Активація процесу аутофагії: який ефект отримуємо
Отже, резюмуючи вищесказане, можна підкреслити, що інвазивні, омолоджуючі процедури, що порушують цілісність шкіри, по суті, є стресовим фактором, тому для отримання повноцінного результату при їх використанні необхідно підтримувати систему, що відповідає за очищення клітин. Пептидний препарат Corebanic сприяє нормалізації аутофагії, здатний підготувати шкіру і посилити ефект апаратних процедур, спрямованих на омолодження. Це наочно показано в вищенаведених дослідженнях, де при ізольованому застосуванні препарату значно знижений фактор запалення в шкірі, який корелює з ознаками старіння. Це дозволяє рекомендувати даний препарат у вигляді монотерапії або першого етапу комплексного омолодження при всіх видах старіння з різним ступенем. Це дозволяє рекомендувати даний препарат у вигляді монотерапії або першого етапу комплексного омолодження при всіх видах старіння з різним ступенем. вираженість регенеративного потенціалу клітин шкіри.
Поєднання ін'єкцій Corebanic з лазерними і радіохвильовими технологіями дозволило достовірно показати потенціюючу дію препарату апаратними методиками, що пов'язано зі своєчасним очищенням клітин і більш правильним їх відновленням після лазерних процедур.
Фактор задоволеності пацієнтіві отримав найвищу оцінку, що є вагомим фактором успіху будь-якої процедури в естетичній медицині.
Добавить комментарий